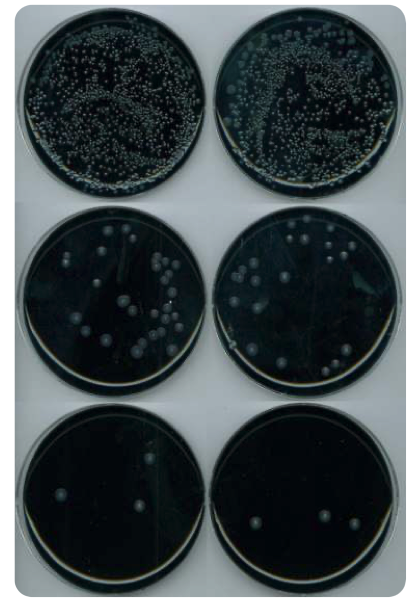
Stacks Image 3329

CLEAN serija - maziva s antimikrobnim aditivima
Više sigurnosti za vaš proces
Čistoća i higijena neophodni su u industriji hrane, pića i farmaceutskih proizvoda kako bi se izbjeglo stvaranje bakterija. Proces čišćenja komponenti, kao što su ležajevi, često može biti vrlo dugotrajan. LUBCON maziva, koja sadrže antimikrobne aditive, mogu se učinkovito koristiti za sprječavanje rasta mikroba.
Clean Serija - Prednosti i Značajke
- H1 - certificiran
- Sprječava rast patogenih mikroba u mazivu
- Nema mikrobne kontaminacije krajnjeg proizvoda u slučaju slučajnog kontakta s mazivom
- Dokazana učinkovitost protiv raznih patogenih klica i plijesni
- Za primjene u kojima rast mikroba može predstavljati značajan rizik i procese s visokim higijenskim zahtjevima
- Inhibira starenje i razgradnju maziva

Na primjeru uzročnika Fusarium oxysporum, dijagram prikazuje stvaranje klica unutar konvencionalne masti u usporedbi s mazivima s antimikrobnim aditivima.
Područja primjene
LUBCON Clean serija posebno je razvijena za primjene s visokim higijenskim zahtjevima. Za te primjene, rast patogenih klica i mikrobna kontaminacija predstavljaju rizik. To uključuje sve procese u kojima su mjere za smanjenje klica, kao što su zagrijavanje, zračenje, sterilizacija ili dodavanje konzervansa, isključene.
Bolnice i medicinske ordinacije
Proizvodnja stočne hrane i hrane za kućne ljubimce
Farmaceutska i kozmetička industrija

Medicinska tehnologija
Industrija hrane i pića
Komercijalne kuhinje
Industrija duhana i luksuzne hrane
Proizvodi serije
LUBCON® Clean
Sintetičke masti visokih performansi
Ulja za reduktore
Hidraulička ulja
Maziva za brtve
Ulja za lance
Primjer:
Čisto podmazivanje ležajeva Turmosynthgrease ALN 1002



